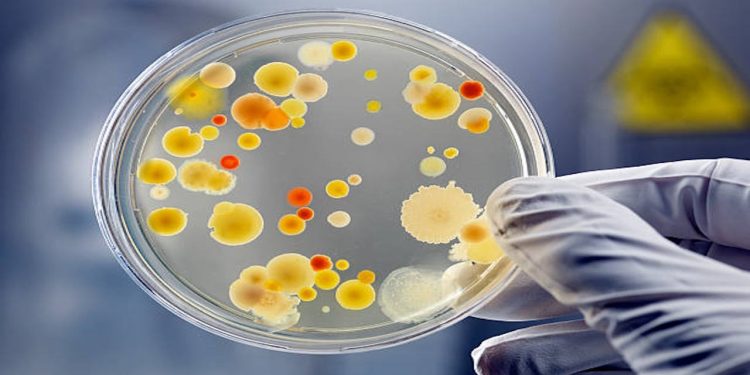
microbi (pexels)

Novità sui microbi: secondo alcuni esperti la maggior parte sarebbero nostri amici, e addirittura potrebbero anche servirci per salvarci la vita. Ecco perchè vanno preservati.
L’ultima rivelazione sui microbi è qualcosa di innovativo rispetto alle credenze che si sono sempre avute. Contrariamente infatti a quanto siamo soliti pensare solo una minimissima parte può portare infezioni e malattie. La gran parte risulta invece essere ‘amica’ dell’uomo, e addirittura sembrerebbe che potrebbero anche salvarci la vita ed essere di fondamentale importanza anche per il nostro pianeta.
Come riporta Il Giornale, grazie agli studi più approfonditi degli ultimi decenni, gli esperti sono in grado di catalogare con maggiore certezza tutte le tipologie di microbi, arrivando alla conclusione che su un trilione di specie, solo 1.400 possono essere dannose per noi. A dirlo sono stati in particolare Duccio Cavalieri, Rino Rappuoli e Lisa Vozza nel saggio “I microbi salveranno il mondo”, che nell’intervista resa a Il Giornale spiegano anche come i microbi siano importanti anche per l’evoluzione degli organismi viventi.
A COSA SERVONO I MICROBI
Un primo aspetto su cui gli esperti si sono voluti concentrare riguarda l’acquisizione dei microbi già in tenera età. Fin da neonati infatti il corpo del bambino, già col parto, entra in contatto con moltissimi batteri, per poi arricchire la propria ‘dote’ nel momento in cui entra in contatto col mondo esterno e con gli alimenti. Ma l’elemento più importante attiene la funzione dei microbi, essenziale nel momento in cui ci hanno dato l’ossigeno, “che non esisterebbe se non fossero apparsi i cianobatteri, degli organismi unicellulari che per primi hanno fatto la fotosintesi, permettendo ad altri organismi di svilupparsi. Ci hanno dato alimenti essenziali nati dalla fermentazione, come birra, vino, pane e yogurt. E, senza microbi, la maggior parte degli organismi viventi non esisterebbe.” Pensiamo poi anche al nostro intestino, che vive di batteri ‘buoni’ di cui necessita per il suo sano funzionamento.
Gli esperti hanno spiegato che in questi anni non si è considerata l’importanza dei microbi perchè ci si è concentrati solo sulle specie pericolose per noi e per il nostro pianeta, quando invece la maggior parte ci serve e va preservata.
MICROBI E ANTIBIOTICI
Gli esperti hanno inoltre voluto affrontare con Il Giornale anche la tematica degli antibiotici, di cui spesso si sente parlare di abuso, e del ruolo che può avere questo ‘modus operandi’ sulla funzionalità dei microbi. In realtà un uso massiccio di antibiotici sembra emergere soprattutto sugli animali, quando ci si potrebbe avvalere di altre metodologie, come ad esempio ci si potrebbe avvalere dei batteriofagi, cioè virus che si nutrono di batteri. Come spiegano gli studiosi “l’idea è di realizzare terapie mirate, ingegnerizzando i batteriofagi, in modo da usare quelli specifici contro le infezioni batteriche resistenti. Per ora sono terapie sperimentali, non banali e costose”.
Alla luce di tutto ciò si può concludere come i batteri siano immortali ma non vadano demonizzati in toto; è importante conoscerli per poter imparare ad usarli nel modo più corretto e anche per poterci salvare la vita.